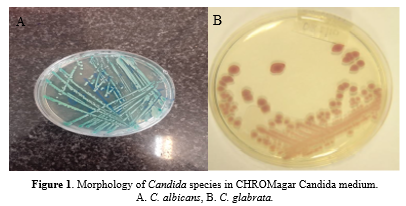

Volume 18, Issue 1 (Jan-Feb 2024)
mljgoums 2024, 18(1): 34-37 |
Back to browse issues page
Download citation:
BibTeX | RIS | EndNote | Medlars | ProCite | Reference Manager | RefWorks
Send citation to:



BibTeX | RIS | EndNote | Medlars | ProCite | Reference Manager | RefWorks
Send citation to:
Alhashem R, Hosseini S S. Epidemiological profile and fluconazole susceptibility of patients with vulvovaginal candidiasis in northeast Iran. mljgoums 2024; 18 (1) :34-37
URL: http://mlj.goums.ac.ir/article-1-1700-en.html
URL: http://mlj.goums.ac.ir/article-1-1700-en.html
1- Laboratory Sciences Research Center, Golestan University of Medical sciences, Gorgan, Iran.
2- Laboratory Sciences Research Center, Golestan University of Medical sciences, Gorgan, Iran. ,hoseini.sedigheh@gmail.com
2- Laboratory Sciences Research Center, Golestan University of Medical sciences, Gorgan, Iran. ,
Full-Text [PDF 521 kb]
(900 Downloads)
| Abstract (HTML) (3615 Views)
Full-Text: (1257 Views)
Introduction
Vulvovaginal candidiasis (VVC) is a disease caused by the abnormal growth of yeast in the vaginal mucosa, which has often been diagnosed in women's clinics in recent years (1).
Vulvovaginal candidiasis is caused by inflammatory changes in the vaginal epithelium due to infection with Candida species, most commonly Candida albicans. Candida is a part of the natural flora in many women and is often asymptomatic. Therefore, VVC requires the presence of Candida in the vagina and swelling, as well as symptoms of irritation, itching, disorientation, or inflammation (2,3).
Several reports have shown that the prevalence of candidiasis in Iran is remarkable and similar to the rest of the world (4-6). However, there are few reports on the sensitivity of antifungal drugs to vaginal isolates. In addition, some studies have shown that there are several treatments for VVC (7).
Based on several reports, resistance to fungi and relapses are serious problems among Iranian patients (8). In a study conducted in Qazvin, Iran, the authors believed that the difference between fluconazole and clotrimazole in recurrent candidiasis was not significant (9). Long-term treatment and increased use of antifungal drugs cause recurrent candidiasis in patients with vulvovaginal disease. Azoles have the benefit of being taken orally, which increases their ability (7,10).
This study aimed to estimate the prevalence of VVC diagnosis in women to identify the epidemiological profile and antifungal susceptibility to fluconazole in the Sayyad Shirazi Hospital, affiliated with Golestan University of Medical Sciences, northeastern Iran.
Methods
This cross-sectional study was performed on 576 suspected vaginitis patients determined by a midwife or gynecologist, referred to Sayyad Shirazi Obstetrics and Gynecology Teaching Hospital, affiliated with Golestan University of Medical Sciences, Gorgan, Golestan Province (Iran) from 2020 to 2022. Information on age, medical history, symptoms, and recurrent VVC (defined as ≥ 4 episodes within a year) was collected (11). Vaginal secretions were collected from the posterior fornix with a sterile cotton swab and put into 3 mL of sterile saline.
Exclusion criteria included women currently menstruating, those who had intercourse in the last 24 hours, individuals who used vaginal creams in the week preceding the study, and those who had vaginal douching within 48 hours post-study. Additionally, individuals who had taken antifungal medication in the past week (as indicated by negative Candida culture) were also excluded. All the specimens were cultured on CHROMagar Candida (CHROMagar Candida, France) for colony color and distinguishing concomitant Candida spp.
The identification was confirmed by germ tube formation, chlamydospore production in cornmeal agar (CMA) (Merck Germany) with 1% Tween 80, and cultured on Sabouraud dextrose agar (SDA; Merck, Germany) and incubated aerobically at 37 ºC for 24-48 hours (7). Candida isolates were prepared for testing.
This study was conducted on 319 clinical samples from VVC obtained from 576 vaginal discharge specimens of women suspected of VVC that were sent to the Mycology Laboratory, Golestan University of Medical Sciences, Grogan, Iran.
Ethical approval for the study was granted by the Golestan University of Medical Sciences Ethics Committee (Approval code: IR. GOUMS. REC. 1400.041).
The VVC isolates were cultured on SDA and then incubated aerobically at 37 ºC for 24-48 hours (7). Candida isolates were identified by the morphological features on a culture medium, CHROMagar Candida (CHROMagar, Chrom, France), and definitive identification was achieved by polymerase chain reaction (PCR), employing specific primers (ITS1 and ITS4) (forward 5′-TCC GTA GGT GAA CCT GCG G-3)′ and ITS4 (reverse, 5′-TCC TCC GCT TAT TGA TAT GC-3′) targeting the fungal 5.8s ribosomal RNA subunit, which is designed for the amplification of the zone of ITS1-5.8S-ITS2 rDNA duplicated using PCR and cut with MSP1(HpaII) enzyme. Production of restriction fragment length polymorphism (RFLP) performed by agarose gel electrophoresis (2).
We used a described disk diffusion by fluconazole (Rosco, France) assay for the susceptibility test of all yeast isolates (7,11,12). The test disks contained 25 µg. They were stored in a desiccator at 4°C. Initially, a yeast inoculum suspension adjusted to match a 0.5 McFarland density standard was prepared. A sterile cotton swab moistened with the inoculum suspension was used to apply to a 90-mm-diameter plate containing Mueller-Hinton agar supplemented with 2% glucose and 0.5 µg/mL methylene blue. The plates were allowed to dry for 5-15 minutes before a 10 µg/mL fluconazole disk was placed in the center of the agar. The plates were incubated for 18-24 hours at 35-37°C, and the slowly growing isolates could be read after 48 hours of incubation. A quality control (QC) strain, C. albicans ATCC 10231, with a recommended acceptable performance range of 32-43 mm, was tested once a week.
Reading and interpretation of zone diameter measurements were performed as follows: All inhibition zone diameters generated by disk diffusion tests were read and recorded by using the BIOMIC Plate Reader System (13), a semiautomatic electronic image-analysis system.
The interpretive breakpoints used for the fluconazole disk diffusion test were based on zones that correlated with the US National Committee for Clinical Laboratory Standards (NCCLS) recommended category breakpoints for the reference broth dilution method. Fluconazole breakpoints were S ≥19 mm, SDD =15-19 mm, and R ≤14 mm by CLSI-M44 indications (5,7).
Descriptive statistics were applied to all our data, using absolute numbers and percentages for qualitative variables and measures of central tendency (mean and standard deviation) for quantitative variables. The chi-square test was performed to explore the associations between variables and diagnosis of candidiasis, with the level of significance set to P < 0.05. A regression analysis was applied at 95% to determine the magnitude of the associations with the diagnosis of candidiasis. Analyses were performed using IBM SPSS Statistics v. 16 (IBM Corp., Armonk, NY, USA).
Results
In total, 576 vaginitis patients were included in the present study, of whom 317 patients aged 18-59 years showed vaginal candidiasis. Most of them were found in isolates of those aged 20-29 years old. Besides, 91% and 9% of cases were VVC and recurrent vulvovaginal candidiasis (RVVC) (Table 1). Those with positive candidiasis had underlying diseases such as diabetes (16%) and hypertension (10%), had a history of fluconazole use (4%), and pregnancy (70%) (Table 2).
C. albicans produced green colonies on CHROMagar Candida chlamydospores on the CMA medium and appeared in the germ tube in the test, as well. CHROMagar Candida (CAC, Becton Dickinson, Heidelberg, Germany) is a differential ready-to-use chromogenic medium designed to identify C. albicans, C. tropicalis, and C. krusei by colony color and morphology. The colonies of C. albicans appear light to medium green, C. tropicalis colonies appear dark blue to metallic blue, and C. krusei appear pink with a whitish border (Figure 1).

The clinical isolates and standard strain of C. albicans ATCC10231 produced bands with an approximate length of 535 bp (Figure 2). Digestion of the ITS region of C. albicans using the MSP1(HpaII) enzyme produced two bands of 297 and 338 bp (Figure 3).
C. albicans strains were reported as susceptible S (Zone diameter ≥ 19 mm), susceptible dose-dependent (SDD) (15 to 18 mm), and resistant R (≤ 14 mm) (Figure 4).



We were able to identify 352 yeast isolates sequentially sent to our laboratory, including the following species: 274 C. albicans (14(4%) fluconazole-resistant), C. glabrata (22 (6%) fluconazole-resistant), C. parapsilosis (7 (2%) fluconazole-resistant), C. tropicalis (6 (1.7%) fluconazole-resistant) C. krusei (2 (0.7%) fluconazole-resistant) (5). The average inhibition zone diameters of fluconazole disk diffusion tests obtained with the different species of Candida are shown in (Table 3).
Discussion
In this study, frequencies of different Candida species were separated; most of the Candida species among VVC were C. albicans isolates (68%, n = 274). Our findings are similar to the previously reported data by Sutra et al. (14). Bradfield Strydom et al. (2014) showed the best recovery of Candida genus in vaginal smear This may be due to processing more vaginal swab samples than high ones in our study urine smear (15).
In the study conducted by Williams et al., the youngest participant was a 1-year-old infant, while the oldest was 52 years old. Candida infection was found to be the highest in the age group of 21-40 years (16). In our study, the maximum isolation of Candida isolates was found in the age group of 18-49 years. The higher rate of fluconazole resistance in females to Candida isolates infection could be due to lower immunity and aging, which is similar to earlier studies reporting the rate of isolation of Candida isolates in females to be about 60% (6).
In the present study, Candida spp. was the most important agent of fungal vaginitis. This finding is in line with the findings of the previous studies that reported C. albicans and C. glabrata as the most frequent pathogenic yeasts in VVC patients (14,17,18). Several studies reported that the percentage of non-Candida albicans (NAC) isolates in vaginitis (7,19) and infections caused by unusual yeasts is on the rise (19). Traditional methods cause difficulties in the definitive diagnosis of the multiplicity of yeast species. Molecular approaches can improve the differentiation of less common yeast isolates and strongly similar yeast species such as those in Candida complexes. RFLP-PCR is most valuable for large epidemiological studies on unusual yeasts. It has been proved that the ITS1-5.8srDNA-ITS2 regions are an accurate approach for the definitive identification of pathogenic yeast species, particularly C. glabrata (14,19) and C. parapsilosis (20).
Mushi et al. (7) investigated C. albicans, C. glabrata, C. tropicalis, and C. parapsilosis isolated from vaginitis patients and reported C. albicans as the main cause of vaginal candidiasis. Several studies conducted in Iran and other countries reported C. albicans as the predominant pathogen in VVC (6,15,18). Another study has reported C. tropicalis as the main species that causes VVC (21). which is not consistent with the current study that found C. glabrata to be the first and most frequently encountered NAC species.
Several studies mentioned C. glabrata as an important NAC species in Candida vaginitis patients (5,11,13). The current study revealed that C. krusei, as a NAC species, is associated with vulvovaginitis. Clinical isolates such as C. krusei and C. glabrata were resistant or showed low susceptibility to azole drugs, as reported by other studies (5,17). C. glabrata is reported as a common fungal pathogen in many countries and appears to be intrinsically resistant to fluconazole.
Other NAC species, such as C. tropicalis, C. parapsilosis, and C. krusei, were isolated from VVC and RVVC patients as well.
In the present study, VVC and RVVC patients were healthy women with a history of exposure to known risk factors such as diabetes, pregnancy, hypertension, and usage of fluconazole. According to clinical studies, most RVVC patients are diabetic women, and multiple recurring infections are often idiopathic without known potential risk factors (22). Numerous studies reported C. albicans as the most prevalent species, even more than NAC species, in vaginal candidiasis patients (22,23). Overall, C. albicans and NAC species had almost similar rates of prevalence (76% versus 24%, respectively). Since NAC species can often be found in RVVC patients and do not respond to standard antifungal therapies, their identification is of crucial importance. The results of this study indicated that C. albicans and C. glabrata are still the principal pathogenic agents in recurrent and non-recurrent Candida vaginitis.
Agar disk diffusion tests with antifungal drugs are not standardized, and a direct correlation between disk diffusion test results and clinical outcomes has not yet been reported. Consequently, antifungal disk diffusion tests should not be used as a guide for the selection and monitoring of antifungal therapy (6). However, considering that disk-diffusion assays are simple to perform and inexpensive, they may be a useful tool in large-scale surveys of clinical isolates to identify population distribution patterns of susceptibility to fluconazole (7,9-12).
As antifungal drug resistance may become more prevalent, it is increasingly important to evaluate current susceptibility profiles and emerging trends (2,19). In our study, most of the clinical yeast isolates were susceptible to fluconazole. However, it is clear that there are some species-specific differences in susceptibility to this antifungal agent. Notably, resistance rates to fluconazole ranged from 0 to 100% of the isolates tested, depending on the species of Candida considered for analysis. In agreement with data reported by other investigators (14,17-20). DDS resistance to fluconazole was most commonly reported among C. glabrata and C. krusei strains. Our data indicate that fluconazole has good in vitro activity against most clinically relevant strains of Candida spp.
Conclusion
C. albicans and C. glabrata are the most important Candida species isolated from VVC and RVVC, which confirms the dramatic incidence of Candida species in VVC patients. Accurate identification of Candida spp. is important for treatment administration because some strains revealed different levels of resistance to antimycotic medicines.
Despite the difficulty in making a reliable estimate of this infection and its associated risk factors, we encourage the scientific community to continue their research on this increasing incidence worldwide to propose prevention strategies for potentially reversible determinants and improve health outcomes for the patients.
Acknowledgement
The current study was extracted from a research protocol approved by Golestan University of Medical Sciences, Gorgan, Iran. The study was approved by the university's Ethics Committee (Code No. IR. GOUMS. REC. 1400.041).
Funding sources
No specific funding was obtained for this work.
Ethical statement
This study was approved by the ethics committee of the Golestan University of Medical (IR.GOUMS.REC.1400.041). All procedures were performed in accordance with the relevant guidelines and regulations.
Conflicts of interest
The authors declare that they have no conflict of interest.
Author contributions
SSH and RA conceived this study. SSH provided samples. SSH designed wet lab experiments. RA carried out wet lab experiments. SSH designed and performed computational analysis, prepared tables and figures, and interpreted the results. SSH and RA offered technical consultation and professional suggestions. SSH and RA wrote the manuscript. All the authors have read and approved the final manuscript.
Vulvovaginal candidiasis (VVC) is a disease caused by the abnormal growth of yeast in the vaginal mucosa, which has often been diagnosed in women's clinics in recent years (1).
Vulvovaginal candidiasis is caused by inflammatory changes in the vaginal epithelium due to infection with Candida species, most commonly Candida albicans. Candida is a part of the natural flora in many women and is often asymptomatic. Therefore, VVC requires the presence of Candida in the vagina and swelling, as well as symptoms of irritation, itching, disorientation, or inflammation (2,3).
Several reports have shown that the prevalence of candidiasis in Iran is remarkable and similar to the rest of the world (4-6). However, there are few reports on the sensitivity of antifungal drugs to vaginal isolates. In addition, some studies have shown that there are several treatments for VVC (7).
Based on several reports, resistance to fungi and relapses are serious problems among Iranian patients (8). In a study conducted in Qazvin, Iran, the authors believed that the difference between fluconazole and clotrimazole in recurrent candidiasis was not significant (9). Long-term treatment and increased use of antifungal drugs cause recurrent candidiasis in patients with vulvovaginal disease. Azoles have the benefit of being taken orally, which increases their ability (7,10).
This study aimed to estimate the prevalence of VVC diagnosis in women to identify the epidemiological profile and antifungal susceptibility to fluconazole in the Sayyad Shirazi Hospital, affiliated with Golestan University of Medical Sciences, northeastern Iran.
Methods
This cross-sectional study was performed on 576 suspected vaginitis patients determined by a midwife or gynecologist, referred to Sayyad Shirazi Obstetrics and Gynecology Teaching Hospital, affiliated with Golestan University of Medical Sciences, Gorgan, Golestan Province (Iran) from 2020 to 2022. Information on age, medical history, symptoms, and recurrent VVC (defined as ≥ 4 episodes within a year) was collected (11). Vaginal secretions were collected from the posterior fornix with a sterile cotton swab and put into 3 mL of sterile saline.
Exclusion criteria included women currently menstruating, those who had intercourse in the last 24 hours, individuals who used vaginal creams in the week preceding the study, and those who had vaginal douching within 48 hours post-study. Additionally, individuals who had taken antifungal medication in the past week (as indicated by negative Candida culture) were also excluded. All the specimens were cultured on CHROMagar Candida (CHROMagar Candida, France) for colony color and distinguishing concomitant Candida spp.
The identification was confirmed by germ tube formation, chlamydospore production in cornmeal agar (CMA) (Merck Germany) with 1% Tween 80, and cultured on Sabouraud dextrose agar (SDA; Merck, Germany) and incubated aerobically at 37 ºC for 24-48 hours (7). Candida isolates were prepared for testing.
This study was conducted on 319 clinical samples from VVC obtained from 576 vaginal discharge specimens of women suspected of VVC that were sent to the Mycology Laboratory, Golestan University of Medical Sciences, Grogan, Iran.
Ethical approval for the study was granted by the Golestan University of Medical Sciences Ethics Committee (Approval code: IR. GOUMS. REC. 1400.041).
The VVC isolates were cultured on SDA and then incubated aerobically at 37 ºC for 24-48 hours (7). Candida isolates were identified by the morphological features on a culture medium, CHROMagar Candida (CHROMagar, Chrom, France), and definitive identification was achieved by polymerase chain reaction (PCR), employing specific primers (ITS1 and ITS4) (forward 5′-TCC GTA GGT GAA CCT GCG G-3)′ and ITS4 (reverse, 5′-TCC TCC GCT TAT TGA TAT GC-3′) targeting the fungal 5.8s ribosomal RNA subunit, which is designed for the amplification of the zone of ITS1-5.8S-ITS2 rDNA duplicated using PCR and cut with MSP1(HpaII) enzyme. Production of restriction fragment length polymorphism (RFLP) performed by agarose gel electrophoresis (2).
We used a described disk diffusion by fluconazole (Rosco, France) assay for the susceptibility test of all yeast isolates (7,11,12). The test disks contained 25 µg. They were stored in a desiccator at 4°C. Initially, a yeast inoculum suspension adjusted to match a 0.5 McFarland density standard was prepared. A sterile cotton swab moistened with the inoculum suspension was used to apply to a 90-mm-diameter plate containing Mueller-Hinton agar supplemented with 2% glucose and 0.5 µg/mL methylene blue. The plates were allowed to dry for 5-15 minutes before a 10 µg/mL fluconazole disk was placed in the center of the agar. The plates were incubated for 18-24 hours at 35-37°C, and the slowly growing isolates could be read after 48 hours of incubation. A quality control (QC) strain, C. albicans ATCC 10231, with a recommended acceptable performance range of 32-43 mm, was tested once a week.
Reading and interpretation of zone diameter measurements were performed as follows: All inhibition zone diameters generated by disk diffusion tests were read and recorded by using the BIOMIC Plate Reader System (13), a semiautomatic electronic image-analysis system.
The interpretive breakpoints used for the fluconazole disk diffusion test were based on zones that correlated with the US National Committee for Clinical Laboratory Standards (NCCLS) recommended category breakpoints for the reference broth dilution method. Fluconazole breakpoints were S ≥19 mm, SDD =15-19 mm, and R ≤14 mm by CLSI-M44 indications (5,7).
Descriptive statistics were applied to all our data, using absolute numbers and percentages for qualitative variables and measures of central tendency (mean and standard deviation) for quantitative variables. The chi-square test was performed to explore the associations between variables and diagnosis of candidiasis, with the level of significance set to P < 0.05. A regression analysis was applied at 95% to determine the magnitude of the associations with the diagnosis of candidiasis. Analyses were performed using IBM SPSS Statistics v. 16 (IBM Corp., Armonk, NY, USA).
Results
In total, 576 vaginitis patients were included in the present study, of whom 317 patients aged 18-59 years showed vaginal candidiasis. Most of them were found in isolates of those aged 20-29 years old. Besides, 91% and 9% of cases were VVC and recurrent vulvovaginal candidiasis (RVVC) (Table 1). Those with positive candidiasis had underlying diseases such as diabetes (16%) and hypertension (10%), had a history of fluconazole use (4%), and pregnancy (70%) (Table 2).
|
Table 1. Distribution of Candida infection according to factors affecting the occurrence of infection
 |
Table 2. Distribution of Candida isolates in vaginal discharge samples according to age groups and the presence of VVC1 and RVVC2 |
The clinical isolates and standard strain of C. albicans ATCC10231 produced bands with an approximate length of 535 bp (Figure 2). Digestion of the ITS region of C. albicans using the MSP1(HpaII) enzyme produced two bands of 297 and 338 bp (Figure 3).
C. albicans strains were reported as susceptible S (Zone diameter ≥ 19 mm), susceptible dose-dependent (SDD) (15 to 18 mm), and resistant R (≤ 14 mm) (Figure 4).



We were able to identify 352 yeast isolates sequentially sent to our laboratory, including the following species: 274 C. albicans (14(4%) fluconazole-resistant), C. glabrata (22 (6%) fluconazole-resistant), C. parapsilosis (7 (2%) fluconazole-resistant), C. tropicalis (6 (1.7%) fluconazole-resistant) C. krusei (2 (0.7%) fluconazole-resistant) (5). The average inhibition zone diameters of fluconazole disk diffusion tests obtained with the different species of Candida are shown in (Table 3).
|
Table 3. Fluconazole category of susceptibility in 352 yeast isolates
 |
Discussion
In this study, frequencies of different Candida species were separated; most of the Candida species among VVC were C. albicans isolates (68%, n = 274). Our findings are similar to the previously reported data by Sutra et al. (14). Bradfield Strydom et al. (2014) showed the best recovery of Candida genus in vaginal smear This may be due to processing more vaginal swab samples than high ones in our study urine smear (15).
In the study conducted by Williams et al., the youngest participant was a 1-year-old infant, while the oldest was 52 years old. Candida infection was found to be the highest in the age group of 21-40 years (16). In our study, the maximum isolation of Candida isolates was found in the age group of 18-49 years. The higher rate of fluconazole resistance in females to Candida isolates infection could be due to lower immunity and aging, which is similar to earlier studies reporting the rate of isolation of Candida isolates in females to be about 60% (6).
In the present study, Candida spp. was the most important agent of fungal vaginitis. This finding is in line with the findings of the previous studies that reported C. albicans and C. glabrata as the most frequent pathogenic yeasts in VVC patients (14,17,18). Several studies reported that the percentage of non-Candida albicans (NAC) isolates in vaginitis (7,19) and infections caused by unusual yeasts is on the rise (19). Traditional methods cause difficulties in the definitive diagnosis of the multiplicity of yeast species. Molecular approaches can improve the differentiation of less common yeast isolates and strongly similar yeast species such as those in Candida complexes. RFLP-PCR is most valuable for large epidemiological studies on unusual yeasts. It has been proved that the ITS1-5.8srDNA-ITS2 regions are an accurate approach for the definitive identification of pathogenic yeast species, particularly C. glabrata (14,19) and C. parapsilosis (20).
Mushi et al. (7) investigated C. albicans, C. glabrata, C. tropicalis, and C. parapsilosis isolated from vaginitis patients and reported C. albicans as the main cause of vaginal candidiasis. Several studies conducted in Iran and other countries reported C. albicans as the predominant pathogen in VVC (6,15,18). Another study has reported C. tropicalis as the main species that causes VVC (21). which is not consistent with the current study that found C. glabrata to be the first and most frequently encountered NAC species.
Several studies mentioned C. glabrata as an important NAC species in Candida vaginitis patients (5,11,13). The current study revealed that C. krusei, as a NAC species, is associated with vulvovaginitis. Clinical isolates such as C. krusei and C. glabrata were resistant or showed low susceptibility to azole drugs, as reported by other studies (5,17). C. glabrata is reported as a common fungal pathogen in many countries and appears to be intrinsically resistant to fluconazole.
Other NAC species, such as C. tropicalis, C. parapsilosis, and C. krusei, were isolated from VVC and RVVC patients as well.
In the present study, VVC and RVVC patients were healthy women with a history of exposure to known risk factors such as diabetes, pregnancy, hypertension, and usage of fluconazole. According to clinical studies, most RVVC patients are diabetic women, and multiple recurring infections are often idiopathic without known potential risk factors (22). Numerous studies reported C. albicans as the most prevalent species, even more than NAC species, in vaginal candidiasis patients (22,23). Overall, C. albicans and NAC species had almost similar rates of prevalence (76% versus 24%, respectively). Since NAC species can often be found in RVVC patients and do not respond to standard antifungal therapies, their identification is of crucial importance. The results of this study indicated that C. albicans and C. glabrata are still the principal pathogenic agents in recurrent and non-recurrent Candida vaginitis.
Agar disk diffusion tests with antifungal drugs are not standardized, and a direct correlation between disk diffusion test results and clinical outcomes has not yet been reported. Consequently, antifungal disk diffusion tests should not be used as a guide for the selection and monitoring of antifungal therapy (6). However, considering that disk-diffusion assays are simple to perform and inexpensive, they may be a useful tool in large-scale surveys of clinical isolates to identify population distribution patterns of susceptibility to fluconazole (7,9-12).
As antifungal drug resistance may become more prevalent, it is increasingly important to evaluate current susceptibility profiles and emerging trends (2,19). In our study, most of the clinical yeast isolates were susceptible to fluconazole. However, it is clear that there are some species-specific differences in susceptibility to this antifungal agent. Notably, resistance rates to fluconazole ranged from 0 to 100% of the isolates tested, depending on the species of Candida considered for analysis. In agreement with data reported by other investigators (14,17-20). DDS resistance to fluconazole was most commonly reported among C. glabrata and C. krusei strains. Our data indicate that fluconazole has good in vitro activity against most clinically relevant strains of Candida spp.
Conclusion
C. albicans and C. glabrata are the most important Candida species isolated from VVC and RVVC, which confirms the dramatic incidence of Candida species in VVC patients. Accurate identification of Candida spp. is important for treatment administration because some strains revealed different levels of resistance to antimycotic medicines.
Despite the difficulty in making a reliable estimate of this infection and its associated risk factors, we encourage the scientific community to continue their research on this increasing incidence worldwide to propose prevention strategies for potentially reversible determinants and improve health outcomes for the patients.
Acknowledgement
The current study was extracted from a research protocol approved by Golestan University of Medical Sciences, Gorgan, Iran. The study was approved by the university's Ethics Committee (Code No. IR. GOUMS. REC. 1400.041).
Funding sources
No specific funding was obtained for this work.
Ethical statement
This study was approved by the ethics committee of the Golestan University of Medical (IR.GOUMS.REC.1400.041). All procedures were performed in accordance with the relevant guidelines and regulations.
Conflicts of interest
The authors declare that they have no conflict of interest.
Author contributions
SSH and RA conceived this study. SSH provided samples. SSH designed wet lab experiments. RA carried out wet lab experiments. SSH designed and performed computational analysis, prepared tables and figures, and interpreted the results. SSH and RA offered technical consultation and professional suggestions. SSH and RA wrote the manuscript. All the authors have read and approved the final manuscript.
Research Article: Research Article |
Subject:
Mycology
Received: 2023/08/14 | Accepted: 2023/10/19 | Published: 2024/02/29 | ePublished: 2024/02/29
Received: 2023/08/14 | Accepted: 2023/10/19 | Published: 2024/02/29 | ePublished: 2024/02/29
References
1. Dadar M, Tiwari R, Karthik K, Chakraborty S, Shahali Y, Dhama K. Candida albicans - Biology, molecular characterization, pathogenicity, and advances in diagnosis and control - An update. Microb Pathog. 2018;117:128-38. [View at Publisher] [DOI] [PMID] [Google Scholar]
2. Scharmann U , Kirchhoff L , Saout Chapot VL , Dziobaka J , Verhasselt HL , Stauf R , et al. Comparison of four commercially available chromogenic media to identify Candida albicans and other medically relevant Candida species. Mycoses. 2020;63(8):823-31. [View at Publisher] [DOI] [PMID] [Google Scholar]
3. Sikora M, Dabkowska M, Swoboda-Kopec E, Jarzynka, Netsvyetayeva I, Jaworska-Zaremba M, et al. Differences in proteolytic activity and gene gene profiles of fungal strains isolated from the total parenteral nutrition patients. Folia Microbiol (Praha). 2011;56(2):143-8. [View at Publisher] [DOI] [PMID] [Google Scholar]
4. Hosseini SS, Yadegari MH, Rajabibazl M, Ghaemi EA. Inhibitory effects of carvacrol on the expression of secreted aspartyl proteinases 1-3 in fluconazole- resistant Candida albicans isolates. Iran J Microbiol. 2016;8(6):401-9. [View at Publisher] [PMID] [Google Scholar]
5. Brandolt TM, Klafke GB, Gonçalves CV, Bitencourt LR, Barral de Martinez AM, Mendes JF, et al. Prevalence of Candida spp. in cervical-vaginal samples and the in vitro susceptibility of isolates. Braz J Microbiol. 2017;48(1):145-50. [View at Publisher] [DOI] [PMID] [Google Scholar]
6. Benedict K, Singleton AL, Jackson BR, Molinari NAM. Survey of incidence, lifetime prevalence, and treatment of selfreported vulvovaginal candidiasis, United States, 2020. BMC Womens Health. 2022;22(1):147. [View at Publisher] [DOI] [PMID] [Google Scholar]
7. Mushi MF, Olum R, Bongomin F. Prevalence, antifungal susceptibility and etiology of vulvovaginal candidiasis in sub-Saharan Africa: A systematic review with meta-analysis and meta-regression. Med Mycol. 2022;60(7):myac037. [View at Publisher] [DOI] [PMID] [Google Scholar]
8. Boros E, Pfliegler WP, Kovács R, Jakab Á, Majoros L, Barta Z, et al. Candida albicans isolates from a single hospital show low phenotypical specialization. J Basic Microbiol. 2017;57(11):910-21. [View at Publisher] [DOI] [PMID] [Google Scholar]
9. Wypij M, Czarnecka J, Dahm H, Rai M. Silver nanoparticles from Pilimelia columellifera subsp. Pallida SL19 strain demonstrated antifungal activity against fungi causing superficial mycoses. J Basic Microbiol. 2017;57(9):793-800. [View at Publisher] [DOI] [PMID] [Google Scholar]
10. Yao D, Chen J, Chen W, Li Z, Hu X. Mechanisms of azole resistance in clinical isolates of Candida glabrata from two hospitals in China. Infect Drug Resist. 2019;12:771-81. [View at Publisher] [DOI] [PMID] [Google Scholar]
11. Gu W, Guo D, Zhang L, Xu D, Sun S. The Synergistic Effect of Azoles and Fluoxetine against Resistant Candida albicans Strains Is Attributed to Attenuating Fungal Virulence. Antimicrob Agents Chemother. 2016;60(10):6179-88. [View at Publisher] [DOI] [PMID] [Google Scholar]
12. Todd JC, Sanford AH, Davidsohn I, Henry JB. Clinical diagnosis and management by laboratory methods. 16th ed. Philadelphia:Saunders;1979. [View at Publisher] [Google Scholar]
13. Bradfield Strydom M, Walpola RL, McMillan S, Khan S, Ware RS, Tiralongo E. Lived experience of medical management in recurrent vulvovaginal candidiasis: A qualitative study of an uncertain journey. BMC Womens Health. 2022;22(1):384. [View at Publisher] [DOI] [PMID] [Google Scholar]
14. Sustr V, Foessleitner P, Kiss H, Farr A. Vulvovaginal Candidosis: Current Concepts, Challenges and Perspectives. J Fungi. 2020;6(4):267. [View at Publisher] [DOI] [PMID] [Google Scholar]
15. Mucci MJ, Cuestas ML, Landanburu MF, Mujica MT. Prevalence of Candida albicans, Candida dubliniensis and Candida africana in pregnant women suffering from vulvovaginal candidiasis in Argentina. Rev Iberoam Micol. 2019;34(2):72-6. [View at Publisher] [DOI] [PMID] [Google Scholar]
16. Willems HME, Ahmed SS, Liu J, Xu Z, Peters BM. Vulvovaginal Candidiasis: A Current Understanding and Burning Questions. J Fungi. 2020;6(1):27. [View at Publisher] [DOI] [PMID] [Google Scholar]
17. Intra J, Sala MR, Brambilla P, Carcione D, Leoni V. Prevalence and species distribution of microorganisms isolated among non-pregnant women affected by vulvovaginal candidiasis: A retrospective study over a 20 year-period. J Mycol Med. 2022;32(3):101278. [View at Publisher] [DOI] [PMID] [Google Scholar]
18. Maraki S, Mavromanolaki VE, Stafylaki D, Nioti E, Hamilos G, Kasimati A. Epidemiology and antifungal susceptibility patterns of Candida isolates from Greek women with vulvovaginal candidiasis. Mycoses. 2019;62(8):692-7. [View at Publisher] [DOI] [PMID] [Google Scholar]
19. Musthafa KS, Hmoteh J, Thamjarungwong B, Voravuthikunchai SP. Antifungal potential of eugenyl acetate against clinical isolates of Candida species. Microb Pathog. 2016;99:19-29. [View at Publisher] [DOI] [PMID] [Google Scholar]
20. Donders G, Sziller IO, Paavonen J, Hay P, de Seta F, Bohbot JM, et al. Management of recurrent vulvovaginal candidosis: Narrative review of the literature and European expert panel opinion. Front Cell Infect Microbiol. 2022;12:934353. [View at Publisher] [DOI] [PMID] [Google Scholar]
21. Jaqueti Aroca J, Ramiro Martínez P, Molina Esteban LM, Fernández González AM, García-Arata I, Prieto Menchero S. Epidemiology and etiology of vulvovaginal candidiasis in Spanish and immigrants' women in Fuenlabrada (Madrid). Rev Esp Quimioter. 2020;33(3):187-92. [View at Publisher] [DOI] [PMID] [Google Scholar]
22. Cooke G, Watson C, Deckx L, Pirotta M, Smith J, van Driel ML. Treatment for recurrent vulvovaginal candidiasis (thrush). Cochrane Database Syst Rev. 2022;1(1):CD009151. [View at Publisher] [DOI] [PMID] [Google Scholar]
23. Sobel JD, Sobel R. Current treatment options for vulvovaginal candidiasis caused by azole-resistant Candida species. Expert Opin. Pharmacother. 2018;19(9):971-7. [View at Publisher] [DOI] [PMID] [Google Scholar]
Send email to the article author
| Rights and permissions | |
 |
This work is licensed under a Creative Commons Attribution-NonCommercial 4.0 International License. |









 goums.ac.ir
goums.ac.ir yahoo.com
yahoo.com